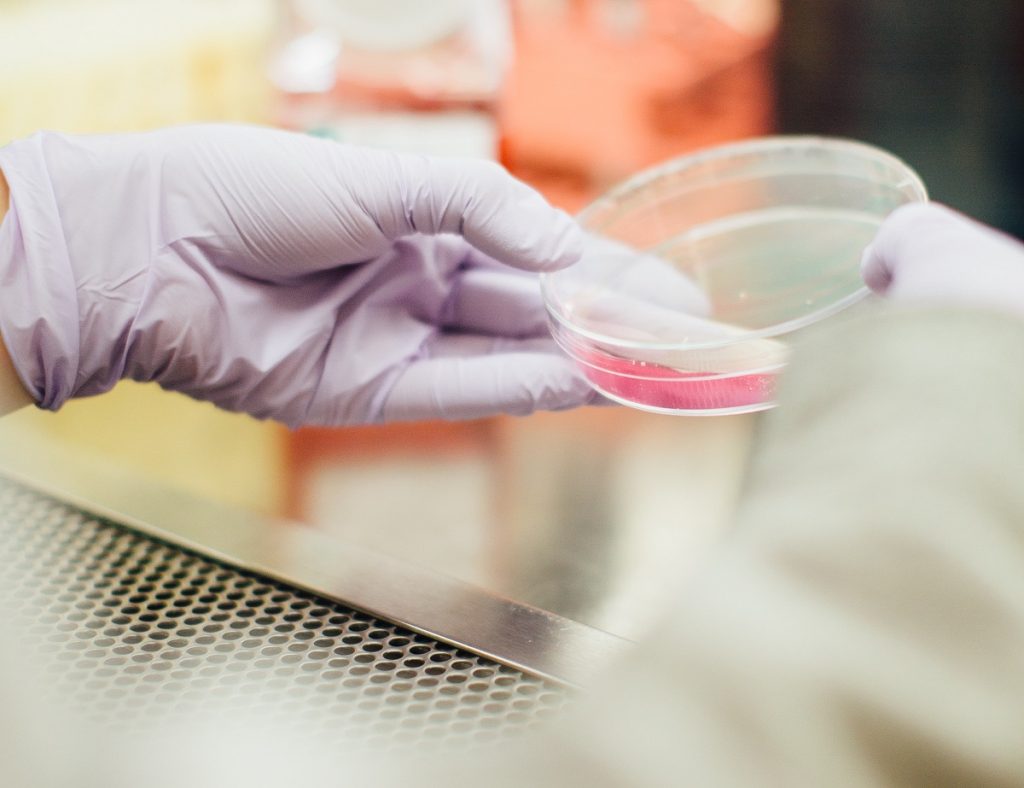
وجود خون در ادرار مردان نشانه چیست؟ آیا خطرناک است؟

وجود خون در ادرار مردان نشانه چیست؟ آیا خطرناک است؟
ناشر: مینویسم (minevisam.ir)
نویسنده: آنت بت خودو
تاریخ انتشار: 10 سپتامبر 2022
تماس با ما: ارسال پیام
وجود خون در ادرار (که به آن هماچوری گفته می شود) به طرز شگفت انگیزی رایج است. در واقع، حدود 13 الی 20 درصد از افراد این را در برهه ای از زندگی خود تجربه می کنند. وجود خون در ادرار ممکن است با چشم غیرمسلح قابل مشاهده باشد، همچنین ممکن است با میکروسکوپ و تنها از طریق آزمایش خون قابل تشخیص باشد. در این مقاله از مینویسم به بررسی علت وجود خون در ادرار مردان چیست و آیا ادرار خونی خطرناک است؟ می پردازیم.
اگرچه این ممکن است در نتیجه دیدن خون در ادرار مردان چیزی خوش خیم باشد، اما ادرار خونی در مردان می تواند نشانه ای از یک شرایط پزشکی جدی تر باشد که نیاز به پیگیری دارد.
این مقاله برخی از شایع ترین دلایل وجود خون در ادرار مردان را بررسی می کند و مرور کلی در مورد نحوه تشخیص و درمان این بیماری ارائه می دهد.
فهرست مطالب دیدن خون در ادرار مردان
علت دیدن خون در ادرار مردان (دلایل رایج)
دیدن خون در ادرار به این معنی است که در جایی از دستگاه تناسلی-ادراری خونریزی وجود دارد. در مردان، این دستگاه شامل اندام هایی از جمله کلیه ها، مثانه، حالب، مجاری ادرار، بیضه ها و غده پروستات است.
برخی از شایع ترین دلایل خون در ادرار مردان عبارت است از:
- هیپرپلازی خوش خیم پروستات: همچنین به عنوان بزرگی پروستات شناخته می شود
- سیستیت یا التهاب مثانه: به عنوان عفونت مثانه نیز شناخته می شود
- مصرف دارو: از جمله پنی سیلین، هپارین، و داروهای شیمی درمانی خاص
- پیلونفریت: همچنین به عنوان عفونت کلیه شناخته می شود
- عفونت های دستگاه ادراری (UTIs): از جمله برخی بیماری های مقاربتی (STDs)
- سنگ کلیه: سنگ کلیه یا مثانه
- ترومای کلیه یا مثانه: شامل صدمات ناشی از ورزش شدید
خلاصه
علل احتمالی هماچوری در مردان عبارتند از عفونت ادراری، عفونت مثانه، عفونت کلیه، سنگ کلیه یا مثانه، بزرگ شدن پروستات و آسیب مثانه یا کلیه. برخی از داروها نیز می توانند باعث ایجاد خون در ادرار شوند.
علل وجود خون در ادرار مردان (دلایل کمتر رایج)
چندین بیماری نادر و اختلال ژنتیکی وجود دارد که موجب خونریزی در دستگاه ادراری می شود.
- گلومرولونفریت: نوعی بیماری مزمن کلیوی
- نفریت لوپوس؛ عارضه بیماری خودایمنی لوپوس که کلیه ها را درگیر می کند
- کم خونی داسی شکل؛ یک اختلال خونی ارثی
- بیماری فون هیپل-لاندو: یکی دیگر از اختلالات ارثی که باعث ایجاد تومورهای غیر سرطانی در کلیه ها، بیضه ها و ستون فقرات می شود.
- سرطان: به طور معمول سرطان پیشرفته کلیه، مثانه یا پروستات
خلاصه
علل غیر معمول هماچوری در مردان شامل بیماری مزمن کلیه، نفریت لوپوس، کم خونی داسی شکل و سرطان مثانه، کلیه یا غده پروستات است.
چگونگی تشخیص خون در ادرار

آزمایش هایی وجود دارند که در صورت ترکیب با معاینه فیزیکی و بررسی سابقه پزشکی به پزشک در ارائه یک تشخیص دقیق کمک می کنند.
آزمایش های خون و ادرار که برای تشخیص هماچوری مورد استفاده قرار می گیرند، عبارتند از:
- تست ادرار: یک آزمایش ساده برای تشخیص وجود خون،
- کشت ادرار: برای شناسایی علت عفونت باکتریایی استفاده می شود،
- تجزیه و تحلیل ادرار: یک آزمایش مبتنی بر ادرار که می تواند پروتئین بیش از حد نشان دهنده بیماری مزمن کلیوی تشخیص دهد،
- آزمایشات STD ادرار: برای تشخیص بیماری های مقاربتی مانند سوزاک یا کلامیدیا استفاده می شود،
- شمارش کامل خون (CBC): آزمایش خونی که می تواند علائم عفونت (بر اساس افزایش گلبول های سفید خون) یا علائم اختلال خون (بر اساس کاهش سطح پلاکت) را تشخیص دهد،
- آزمایش های شیمیایی خون: مجموعه ای از آزمایش های خون که می تواند به تشخیص مشکل در کلیه ها کمک کند.
بسته به دلیلی که پزشک به آن شک کرده است، ممکن است آزمایش های دیگری تجویز شود که عبارتند از:
- پیلوگرام داخل وریدی: یک آزمایش اشعه ایکس که در آن یک رنگ مبتنی بر ید به داخل ورید تزریق می شود تا ناهنجاری های دستگاه تناسلی ادراری را تشخیص دهد.
- سیستوسکوپی: یک ابزار تصویربرداری که شامل قرار دادن لوله فیبر نوری انعطاف پذیر در مجرای ادرار برای نمایش مثانه است.
- اولتراسوند: یک ابزار غیرتهاجمی تصویربرداری است که از امواج صوتی استفاده می کند تا مشکلات دستگاه تناسلی ادراری مانند سنگ کلیه یا بزرگ شدن پروستات را تشخیص دهد.
- توموگرافی کامپیوتری (CT): یک فناوری تصویربرداری که چندین تصویر اشعه ایکس را برای ایجاد «برش های» سه بعدی از اندام های داخلی ترکیب می کند.
خلاصه
تشخیص هماچوری معمولاً شامل معاینه فیزیکی، بررسی سابقه پزشکی و آزمایش های مختلف ادرار و خون است. در صورت نیاز، آزمایشات تصویربرداری مانند اولتراسوند، پیلوگرام داخل وریدی یا سیستوسکوپی ممکن است انجام شود.
درمان خون در ادرار مردان
درمان دیدن خون در ادرار یا هماچوری بر اساس تشخیص دلیل زمینه ای آن تشخیص داده می شود. درمان برخی از دلایل شایع تر عبارتند از:
- آنتی بیوتیک برای عفونت های ادراری، سیستیت، پیلونفریت و بیماری های مقاربتی باکتریایی
- داروهای BPH مانند فلوماکس (تامسولوسین) یا پروسکار (فیناستراید)
- قطع یا تنظیم دوز برای داروهایی که باعث هماچوری می شوند
- شاک ویو تراپی یا درمان های دیگر برای سنگ مثانه یا کلیه
- جراحی برای آسیب شدید کلیه مثانه
سایر درمان ها با بیماری مزمن کلیوی، بیماری خودایمنی، شرایط ژنتیکی و سرطان در ارتباط است. مهم است توجه کنید که مقدار خون در ادرار هیچ ارتباط مستقیمی با میزان جدی بودن اختلال ندارد.
خلاصه
درمان هماچوری می تواند با توجه به اینکه علت عفونت، مثانه یا سنگ کلیه، بزرگ شدن پروستات یا داروهایی که مصرف می کنید متفاوت باشد. مقدار خون در ادرار هیچ ارتباطی با شدت بیماری ندارد.
همچنین بخوانید: مشکلات ادراری افراد دیابتی
کلام آخر
وجود خون در ادرار که با نام هماچوری نیز شناخته می شود، در میان مردان شایع است. دلایل شایع عبارتند از بزرگ شدن پروستات، عفونت های مجاری ادرار، عفونت های مثانه، عفونت های کلیوی، سنگ کیله یا مثانه، آسیب به مثانه یا کلیه و مصرف برخی از داروهای خاص. دلایل کمتر رایج این مشکل عبارتند از بیماری مزمن کلیوی، لوپوس، سرطان و اختلالات ژنتیکی مانند کم خونی سلول داسی شکل.
هماچوری با معاینه فیزیکی، بررسی سابقه پزشکی و آزمایش های ادرار و خون تشخیص داده می شود. بر اساس علتی که پزشک به آن مشکوک شده است، ممکن است آزمایش های تصویربرداری مانند اولتراسوند یا پیلوگرام داخل وریدی تجویز شود. درمان هماچوری بر اساس علت زمینه ای انجام می شود.
سوالات متداول
شایع ترین دلایل عبارتند از سنگ کلیه و حالب یا عبور لخته های خون که از حالب نشئت گرفته است.
سرطان در کلیه، مثانه یا پروستات می تواند موجب بروز خون در ادرار شود.






